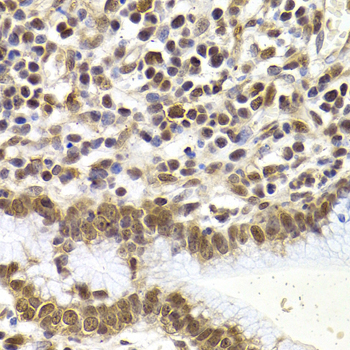

For quotations, please use our online quotation form, and you may also contact us by
service@kendallscientific.com
+1-888.733.6849 (Toll-free)
+1-617.299.7367 (Int’l))
+1-888.733.6849
Our customer service representatives are available 24 hours, Monday through Friday to assist you.| Reactivity | Human Mouse Rat |
| Tested applications | WB IHC IF |
| Recommended Dilution | WB 1:500 - 1:2000 IHC 1:50 - 1:200 IF 1:50 - 1:200 |
| Calculated MW | 52kDa |
| Observed MW | Refer to Figures |
| Immunogen | Recombinant protein of human SMAD1 |
| Storage Buffer | Store at -20℃. Avoid freeze / thaw cycles. Buffer: PBS with 0.02% sodium azide, 50% glycerol, pH7.3. |
| Concentration | r |
| Synonym | SMAD1;BSP1;JV4-1;JV41;MADH1;MADR1 ; |

Western blot analysis of extracts of various cell lines,using SMAD1 antibody.
Immunohistochemistry of paraffin-embedded human stomach cancer using SMAD1 antibody at dilution of 1:200 (400x lens).

Immunohistochemistry of paraffin-embedded rat brain using SMAD1 antibody at dilution of 1:100 (x400 lens).

Immunohistochemistry of paraffin-embedded human kidney using SMAD1 antibody at dilution of 1:100 (x400 lens).

Immunofluorescence analysis of HeLa cell using SMAD1 antibody. Blue: DAPI for nuclear staining.

Immunofluorescence analysis of HeLa cell using SMAD1 antibody. Blue: DAPI for nuclear staining.
Bone morphogenetic proteins (BMPs) constitute a large family of signaling molecules that regulate a wide range of critical processes including morphogenesis, cell-fate determination, proliferation, differentiation, and apoptosis (1,2). BMP receptors are members of the TGF-β family of Ser/Thr kinase receptors. Ligand binding induces multimerization, autophosphorylation, and activation of these receptors (3-5). They subsequently phosphorylate Smad1 at Ser463 and Ser465 in the carboxy-terminal motif SSXS, as well as Smad5 and Smad8 at their corresponding sites. These phosphorylated Smads dimerize with the coactivating Smad4 and translocate to the nucleus, where they stimulate transcription of target genes (5).MAP kinases and CDKs 8 and 9 phosphorylate residues in the linker region of Smad1, including Ser206. The phosphorylation of Ser206 recruits Smurf1 to the linker region and leads to the degradation of Smad1 (6). Phosphorylation of this site also promotes Smad1 transcriptional action by recruiting YAP to the linker region (7).
N/A